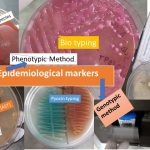

Tag: phage typing
Epidemiological Markers: Introduction, Types and Applications
 Introduction of Epidemiological Markers Epidemiological markers are Important to analyze multiple...
Introduction of Epidemiological Markers Epidemiological markers are Important to analyze multiple...
Introduction of Epidemiological Markers Epidemiological markers are Important to analyze multiple...
Introduction of Epidemiological Markers Epidemiological markers are Important to analyze multiple...